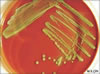

| İnkubasyon Suresi |
İnkubasyon Suresi |

İnkubasyon Suresi |
| Gelişme süresi.Bir mikroorganizmanın gelişmesini tamamlaması için belirli sıcaklık ve belirli atmosfer ortamında tutulma süresi. Vücuda giren bir mikroorganizmanın hastalık oluşturması için geçen süre |